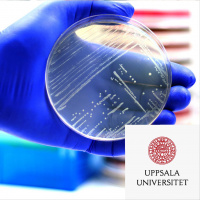
#71 Kampen mot antibiotikaresistens

Forskarpodden Jonas Och Niklas Klampar In I Forskarvärlden
- Autor: Vários
- Narrador: Vários
- Editora: Podcast
- Duração: 52:16:48
- Mais informações
Informações:
Sinopse
I Forskarpodden lyssnar du på samtal om aktuell, spännande och viktig forskning. Niklas Norén och Jonas Löfvenberg möter forskare vid Uppsala universitet och pratar om vad de gör på jobbet. Hur blev de forskare? Vad handlar forskningen om? Och hur bidrar forskningen till att lösa samhällsproblem?
Episódios
-
#82 Målsökande läkemedel mot cancer
14/02/2024 Duração: 25minMålsökande radioaktiva läkemedel är ett effektivt sätt att komma åt spridd cancersjukdom och behandlingen kan skräddarsys för varje patient. Marika Nestor är professor vid institutionen för immunologi, genetik och patologi. Hon är både cancerforskare och innovatör, just nu med två läkemedel under utveckling.
-
#81 Med kroppens kemi i fokus
14/11/2023 Duração: 26minVad händer i kroppens celler vid sjukdom, graviditet och andra processer? I dag kan vi få en djupare förståelse av kroppens kemi, med hjälp av teknik som blir allt känsligare och snabbare. Ingela Lanekoff, professor i kemi, tar fram nya metoder inom masspektrometri som kan användas för att följa förändringar i enskilda celler.
-
#80 Olika åsikter – en väg till kunskap
25/10/2023 Duração: 31minI dagens polariserade debattklimat är det lätt att fastna i sina åsikter och då är risken stor att samtalet inte leder någonstans. Men det går att hitta ett annat, mer prövande förhållningssätt. Folke Tersman, professor i praktisk filosofi, har skrivit en bok om åsikter och kunskap tillsammans med läkaren och författaren Stefan Einhorn. Huvudbudskapet i boken är att vi kan öka vår förmåga att betrakta åsikterna utifrån och undvika att betrakta dem som sanningar.
-
#79 Livsstil och miljö – en grogrund för infektioner
04/10/2023 Duração: 32minVi kan vänta oss fler pandemier efter covid-19. Med ständigt nya kontaktytor mellan människor, djur och miljö, kan virus mutera och hitta nya arter att infektera. Samtidigt kan läkemedelsrester i naturen påverka resistensutveckling hos bakterier, så att antibiotika och andra läkemedel inte fungerar, berättar Josef Järhult, professor i infektionssjukdomar. För att göra något åt dessa globala problem krävs ett helhetsgrepp på vår hälsa, som forskarna kallar ”One Health”
-
#78 Djurs dna ger ny kunskap om sjukdomar
31/05/2023 Duração: 32minALS, tvångssyndrom, lupus, cancer… Genom att kartlägga djurs dna kan vi få en djupare förståelse av biologin bakom sjukdomar. Det internationella forskningsprojektet Zoonomia har undersökt arvsmassan hos 240 olika däggdjur. Kerstin Lindblad-Toh, professor i komparativ genomik, berättar om alla olika upptäckter som forskarna gjort.
-
#77 Monsterstjärnor och sökande efter utomjordiska civilisationer
03/05/2023 Duração: 32minHur det tidiga universum såg ut är fortfarande inte helt klarlagt. I teorin borde det till exempel bland annat ha funnits extremt mycket massivare stjärnor än idag. Erik Zackrisson, docent i astronomi, hoppas nu att med hjälp av det nya, avancerade James Webb-teleskopet för första gången kunna observera de här monsterstjärnorna. En annan fråga som han också söker svar på är om det finns avancerade civilisationer där ute i rymden.
-
#76 AI kan ge säkrare hjärtdiagnoser
19/04/2023 Duração: 37minMed specialtränade AI-algoritmer blir det lättare att ställa diagnos vid hjärtsjukdomar, tack vare tvärvetenskaplig forskning. Det är bara en av alla nya möjligheter med den nya AI-tekniken. Men forskarna behöver också väga möjligheter mot risker, berättar Johan Sundström, hjärtläkare och professor i epidemiologi, och Thomas Schön, professor i artificiell intelligens.
-
#75 Vart är den muslimska världen på väg?
29/03/2023 Duração: 29minVi har under de senaste åren sett hur folk i muslimska länder protesterar mot sina regimer och kräver mänskliga fri- och rättigheter. Samtidigt ser vi i den här delen av världen ett spirande intresse för miljö- och klimatfrågor där religiösa tänkare finner stöd i den muslimska skapelseberättelsen för att tala om människans skyldighet att förvalta vår jord på ett ansvarsfullt sätt för kommande generationer. Vad är det egentligen som händer i den muslimska världen just nu? Medverkande: Mohammad Fazlhashemi, professor islamisk teologi och filosofi vid teologiska institutionen vid Uppsala universitet.
-
#74 AI, digitalisering och arbetsmiljö
15/03/2023 Duração: 30minHur påverkar den nya AI-tekniken arbetsmiljön och vårt engagemang på jobbet? Åsa Cajander är professor i människa-datorinteraktion och har forskat i tjugo år om digitalisering och arbetsmiljö. Nu ska hon studera hur AI används på olika arbetsplatser. För att lyckas med digitalisering på arbetet krävs kunskap inte bara om tekniken utan också om människor.
-
#73 Kaos eller kontroll över livet
01/03/2023 Duração: 24minVad är det som gör att vissa personer klarar motgångar och kriser bättre än andra? Det handlar mycket om självregleringsförmåga. Det vill säga förmågan att medvetet kunna kontrollera sina tankar, känslor och beteenden. Det handlar också om att ha psykologisk flexibilitet. Det vill säga kunna anpassa sig efter den aktuella situation man befinner sig i. Men går det här att träna upp?
-
#72 Hälsovikt för barn
01/12/2022 Duração: 31minÖvervikt hos barn blir allt vanligare. Vad kan man göra som förälder för att hjälpa sitt barn till en mer hälsosam vikt? Det är enklare att börja tidigt med små förändringar än att göra insatser i tonåren, berättar Paulina Nowicka, professor i kostvetenskap. Föräldrarna behöver ha "svart bälte" i tålamod och involvera hela familjen – även mormor, förskolan och grannen.
-
#71 Kampen mot antibiotikaresistens
17/11/2022 Duração: 34minAtt bakterier blir resistenta mot antibiotika är ett växande problem i hela världen. För att få fram nya fungerande antibiotika och ge mer träffsäker behandling behövs både forskning och samarbete med industrin. Möt Dan I Andersson, professor i medicinsk bakteriologi, och Anders Karlén, professor vid institutionen för läkemedelskemi. De forskar båda om antibiotikaresistens, fast ur olika perspektiv
-
#70 Vår sköra demokrati
02/11/2022 Duração: 32minUnder de senaste åren har det allt oftare hörts varningar om att demokratin i världen är hotad. I flera länder, även i Europa, har oberoende medier fått allt svårare att verka, auktoritära ledare tar kontroll över domstolarna och det görs inskränkningar i de mänskliga rättigheterna. Men skulle det kunna hända även här i Sverige? Hur skyddad är egentligen vår demokrati?
-
#69 Nästa generations solceller
19/10/2022 Duração: 26minAnvändningen av solceller ökar och solenergi kan snart gå om kärnkraft på en global nivå. Forskare världen över jobbar med att förbättra solcellernas verkningsgrad, bland annat genom att kombinera olika tekniker i så kallade tandemsolceller. Marika Edoff, professor i fasta tillståndets elektronik, leder två stora samarbetesprojekt mellan akademi och industri: det nationella kompetenscentrumet SOLVE som fokuserar på solcellsutbyggnaden i Sverige och EU-projektet SITA, som utvecklar nästa generations solceller med tandemteknik.
-
#68 Hur ställer vi om till ett fossilfritt samhälle?
05/10/2022 Duração: 32minFör att vi ska nå klimatmålen behöver alla dra sitt strå till stacken. Alla från politiker till näringsliv och konsumenter måste fatta kloka och välavvägda beslut. Mycket görs, men varför går omställningen så långsamt? Och hur skapar vi förutsättningar för att målen i Parisavtalet ska kunna nås? Mikael Karlsson är universitetslektor i klimatledarskap vid institutionen för geovetenskaper vid Uppsala universitet.
-
#67 Ukrainaforskning – mitt i händelsernas centrum
21/04/2022 Duração: 46minLi Bennich Björkman, skytteansk professor i vältalighet och statskunskap har under många år forskat om utvecklingen i Östeuropa och specifikt om Ukraina, vilket nu satt hennes forskning i händelsernas centrum. Idag bidrar hon med sin kunskap för att förstå bakomliggande orsaker till Rysslands invasion av Ukraina. Men det är med dubbla känslor hon ser det nyväckta intresset för landet, dess historia, människor och kultur – ett land där den ryska militären i sin framfart, gör sitt yttersta för att förstöra så mycket som möjligt.
-
#66 Kalla magneter – en framtidsbransch
07/04/2022 Duração: 26minKalla magneter är miljövänliga, energisnåla och supraledande magneter som kan användas vid stora forskningsanläggningar, men också inom medicin och andra områden. För att lyckas tillverka dem krävs samarbete mellan forskare och industrin. Maja Olvegård, forskare i fysik, leder ett samverkansprojekt i samarbete mellan Uppsala universitet, Linnéuniversitetet och högteknologiska företag i Småland.
-
#65 När ryggradsdjuren klev upp på land
24/03/2022 Duração: 39minFör knappt 400 miljoner år sedan kravlade en grupp fiskar upp på land och gav upphov till de fyrbenta ryggradsdjuren. Per Ahlberg, professor i evolutionär organismbiologi har länge forskat om de här varelserna som kallas tetrapoder och är alla groddjurs, reptilers, fåglars och däggdjurs gemensamma förfäder.
-
#64 Pseudovetenskap och minnets uppkomst
11/03/2022 Duração: 34minDesinformation och pseudovetenskap sprids av många orsaker. I bakgrunden finns ofta kommersiella, ideologiska eller politiska intressen. Forskare har ett viktigt ansvar att reagera och bemöta detta, menar Dan Larhammar, professor i molekylär cellbiolog och ordförande i Kungliga Vetenskapsakademien. Han har ägnat mycket tid åt att föra ut forskningsbaserad kunskap och bekämpa desinformation och pseudovetenskap. Som forskare studerar han hjärnans evolution. Hur uppstod till exempel långtidsminnet? Och vad kan vi lära oss av att studera zebrafiskars minne?
-
#63 Vaccin mot cancer
24/02/2022 Duração: 32minImmunterapi med biologiska läkemedel är en kraftfull metod att bekämpa cancer, vid sidan av cellgifter och operation. Till exempel utvecklas vaccin mot cancer, som sätter igång kroppens eget immunförsvar och fungerar på flera olika typer av cancer. Möt cancerforskaren och entreprenören Sara Mangsbo som befinner sig mitt i den spännande utvecklingen.